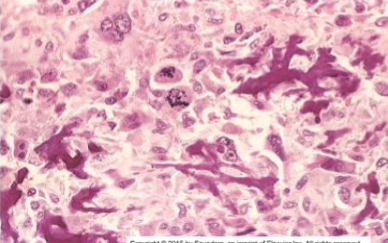
term image

Lecture 13: Bone Tumors
1/53
There's no tags or description
Looks like no tags are added yet.
Name | Mastery | Learn | Test | Matching | Spaced | Call with Kai |
|---|
No analytics yet
Send a link to your students to track their progress
54 Terms
Osteomas
Skull & facial bones
Young adults or middle years
Solitary
Multiple osteomas → Gardner syndrome
Multiple colon polyps at young age → carcinoma
Familial; APC gene mutation
Benign, slow growing tumor
Asymptomatic but symptoms related to nerve impingement
nasal stuffiness; exophthalmos
Osteoid Osteoma
Benign bone producing tumors
M > F, Young (teens & 20’s)
Malignant transformation is very rare
<2 cm in diameter
Mostly asymptomatic but can present with pain with classic triad
Severe localized pain (due to nerves in tumor & prostaglandins produced by osteoblasts)
Pain occurs at night
Pain relieved by aspirin
Femur or Tibia (mostly in cortex)
Osteoid Osteoma X-ray
Target-like radiolucent lesion (actual tumor or nidus which may be centrally mineralized) which is sharply demarcated with surrounding rim of thick/dense reactive cortical bone

Osteoid Osteoma
Osteoid Osteoma Morphology
Round to oval well circumscribed mass
Hemorrhagic or tan, gritty tissue
Randomly interconnecting trabeculae of woven bone lined by single layer of osteoblasts with benign features & surrounding stroma with loose connective tissue & dilated capillaries
Osteosarcoma
Malignant tumor of osteoblasts producing osteoid matrix or mineralized bone
M > F (1.6 : 1)
Teenagers ( < 20 years ) - classic type
Elderly: secondary osteosarcomas
Primary osteosarcoma
Secondary osteosarcoma (secondary to preexisting disorders in the bone): Paget disease of bone, Bone infarcts, Prior radiation to bone
Familial associations: Hereditary Retinoblastoma with germline mutation in RB gene have greater risk of developing osteosarcoma
Primary Osteosarcoma
Metaphysis of long bones
Distal femur or proximal tibia (knee)
Osteosarcoma Clinical
Painful, present as progressively enlarging mass
Fracture may be the first indication
Radiography:
Large, destructive, mixed lytic & sclerotic mass with infiltrative margins
Extension through the cortex lifts periosteum→ reactive sub-periosteal bone formation → Codman triangle
Sunburst pattern of calcified osteoid
lung metastasis
Osteosarcoma Morphology
Solitary
bulky gritty gray-white tumor with hemorrhage & cystic degeneration
Arises in metaphysis of long bones
Spreads through intramedullary canal
Destroys overlying cortex & “blows through” into surrounding soft tissue
May enter the joint
Formation of osteoid matrix or mineralized bone (fine or lace-like pattern or broad sheets of trabeculae) by malignant pleomorphic (large hyperchromatic nuclei, bizarre giant cells) tumor cells (osteoblasts) with abundant mitosis
Osteochondroma
Arises as lateral projection of growth plate with stalk (disorganized growth plate)
Metaphysis of long bones & knee
Pelvis, scapula, ribs occasionally
Tumor stops growing when patient stops growing (at time of growth plate closure)
M > F
Solitary, sporadic – late adolescent to adulthood
Osteochondroma Clinical
slow growing tumor
non-tender
Painful if impinge on nerve or due to fracture of the stalk
Risk of malignant transformation is rare if solitary
1 to 20 cm in size
Sessile or pedunculated & can be mushroom shaped attached to underlying bone by bony stalk
Medullary cavity of stalk continuous with that of underlying bone from which it arises
Covered with cap of benign hyaline cartilage
Undergoes endochondral ossification with new bone formation
Enchondroma
Benign tumors of hyaline cartilage
Enchondroma arise within medullary cavity of metaphysis of Tubular bones of hand & feet
20 to 50 years age
Usually solitary but can be multiple (enchodromatoses) in Ollier-disease & Maffucci-syndrome (non-hereditary disorders)
Mostly asymptomatic
Occasionally cause fracture → pain
may be numerous & large causing severe deformity
Solitary enchondroma rarely undergoes malignant transformation
Enchondromatoses does undergo malignant transformation
Circumscribed radiolucent lesion with central irregular calcifications, sclerotic rim with 0 ring sign, scalloped/thinned intact overlying cortex
Multiple Enchondromas
frequent sarcomatous (chondrosarcoma) transformation)
Ollier disease: non-hereditary sporadic disorder with multiple enchondromas
Maffuci syndrome:
Multiple enchondromas PLUS spindle cell hemangiomas of soft tissues
Risk for ovarian cancer & brain (gliomas)
Chondroblastoma
benign tumor of teenagers
M > F
Arise in epiphysis of long bones close to joints
Painful; impair joint motility; produce joint effusion
Osteolytic lesion on x-ray
Chondromyxoid Fibroma
benign neoplasm of teenagers
Bones of leg, arms, feet, hands, fingers & toes
Comprised of chondroid, myxoid & fibrous tissue
Radiographic features: Expansile, lobulated, lytic lesion of metaphysis of long bones
Chondrosarcoma
Malignant cartilage producing tumor
Conventional (hyaline cartilage producing), clear cell, dedifferentiated & mesenchymal variants
Primary Conventional: Central (Intramedullary) or peripheral (Juxtacortical)
40s or older
M > F
Axial skeleton – pelvis (hip joint), shoulder, sternum, ribs
Epiphysis of long tubular bones – clear cell variant (younger age)
Distal extremities rarely involved
Secondary chondrosarcoma arise from:
Pre-existing enchondroma (Ollier & Maffucci syndrome; IDH mutations), or osteochondroma (EXT1/2 mutations)
Post radiation
Chondrosarcoma Morphology
Composed of glistening gray white translucent cartilage nodules along with gelatinous or myxoid areas
Neoplastic cartilage/chondrocytes infiltrate marrow space
Spotty calcifications in matrix
Destroy cortex & extend into soft tissue around bone
Chondrosarcoma
Painful, enlarging masses
X-ray:
Radiolucent, nodular mass with poorly defined borders
Foci of flocculent densities (calcified matrix)
Ewing Sarcoma
Malignant/aggressive bone tumor of small round blue cells without differentiation
t(11:22) translocation → fusion of FLI1 gene
<20 years
whites
M > F
Painful enlarging mass
Affected site is often tender, warm & swollen
Fever, anemia, ↑ ESR, leukocytosis
Can spread to lungs, other bones/bone marrow
Giant cell tumor/Osteoclastoma
Benign but locally aggressive
adults in 30 to 50; mostly females
Epiphyses of long bones near joints & may extend to metaphysis 50% around knee
Most are solitary
Neoplastic cells are primitive mononuclear osteoblast precursors
Arthritis like symptoms – joint swelling & pain
Can present as pathologic fracture
Fibrous dysplasia
Benign lesion
Localized area of bone developmental arrest- all components of normal bone present but fail to differentiate into mature structures
Monostotic: single bone involvement → majority
Polyostotic: multiple bone involvement- Disease is evident earlier & more likely craniofacial involvement with deformity
Mazabraud syndrome: mostly polyostotic fibrous dysplasia & soft tissue myxomas
McCune-Albright syndrome
Monostotic Fibrous dysplasia Clinical
Femur, tibia, ribs, jaw bones, calvarium & humerus
Boys = girls; early adolescence; lesions stop enlarging at the time of growth plate closure
asymptomatic
May cause pain or fracture or discrepancies in limb length due to bone enlargement & disfigurement
Polyostotic Fibrous dysplasia Clinical
Disease is evident slightly earlier age than monostotic type
Bones affected: femur, skull, tibia, humerus, ribs, fibula, radius, ulna, mandible & vertebra
More likely craniofacial involvement with deformity
Crippling bone deformities & fractures
Malignant transformation into sarcoma is rare
McCune-Albright syndrome
Precocious puberty
Hyperthyroidism, pituitary adenomas, primary adrenal hyperplasia
Polyostotic fibrous dysplasia often unilateral
Skin pigmentation: large macules with irregular borders
Dark to Café-au-lait in color
Fibrous dysplasia Morphology
Curvilinear chinese letter or C or W shaped trabeculae of woven bone in cellular fibroblastic proliferation
trabeculae lack prominent osteoblast rim
Radiograph: Intramedullary lytic lesion in diaphysis with well defined margins & thin rim of sclerotic bone & expansion of bone with ground glass appearance
Multiple Myeloma
Most common primary malignancy of bone
Malignant neoplasm of Plasma cells
Plasma cell tumors involving axial skeleton such as skull, vertebra → lytic bone lesions as punched-out defects on x-ray → fractures
Hypercalcemia
Renal failure
Acquired immune abnormalities
Serum & urine “M” spike (high levels of M protein)
↑ levels of monoclonal IgG in the blood
↑ IgA
light chains in urine – Bence jones proteins
Anemia: Rouleaux formation of RBCs on blood smear due to ↑ protein in serum
Amyloidosis AL type due to free light chains deposit in tissue
Multiple Myeloma Pathogenesis
IL-6 is produced by tumor cells & resident marrow stromal cells
IL-6 → plasma cells proliferation & immunoglobulin production
MIP1 alpha derived from myeloma cells regulates RANKL→ osteoclast activation
Wnt pathway modulators released by tumor cells are potent inhibitors of osteoblast function
What tumors comprise the most common sources of bone metastasis?
Adults: Prostate, Breast, Kidney & thyroid- solitary metastasis, Lung
Children: Neuroblastoma, Wilm’s tumor, Osteosarcoma, Ewing sarcoma, Rhabdomyosarcoma
Osteoblastic metastasis
serum alkaline phosphatase (ALP) ↑; normal serum Calcium
Prostate in males
Multiple osteoblastic metastasis of lumbar vertebral bodies & pelvis
Radiodense, sclerotic bone
Growth factors from tumor cells stimulate osteoblasts – TGF beta, FGF, PDGF
Osteolytic metastasis
serum calcium ↑
Kidney & thyroid – single metastasis
Lung, GIT, breast & malignant melanoma – multiple metastasis
Radiolucent bone on radiographs
PTH-rP, cytokines IL-6, MIP1-a (myeloma) activate osteoclasts

Osteoid Osteoma

Osteoid Osteoma

Osteosarcoma

Osteosarcoma

Osteosarcoma

Osteosarcoma
Osteosarcoma

Osteosarcoma

Osteochondroma

Osteochondroma

Osteochondroma

chondrosarcoma

chondrosarcoma

chondrosarcoma

chondrosarcoma

chondrosarcoma

chondrosarcoma

osteosarcoma

osteosarcoma

Fibrous Dysplasia

Fibrous Dysplasia

Fibrous Dysplasia

Fibrous Dysplasia

Fibrous Dysplasia